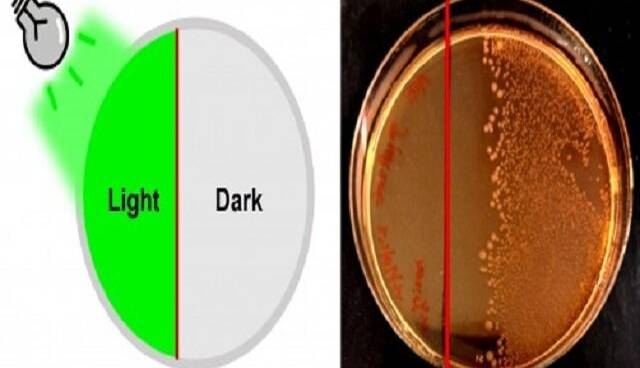
news1

دوشنبه 05 اسفند 1404 - 04:02
بروزترین اخبار
- آخرین اخبار
- آخرین مطالب استان ها
-
مکلارن تسلیم شد، ابرشاسیبلند هیبرید برای رقابت با فراری ساخته میشود
-
حریق خودروی پراید در الهیه جنوبی بندرعباس
-
10 رینگ معروف در صنعت خودرو؛ کدام یک انتخاب شماست؟
-
جریمه قاچاقچی حوله تنظیف در اندیمشک
-
معاون رئیسجمهور: بهرهبرداری ناپایدار تهدیدی برای محیطزیست چهارمحال وبختیاری است
-
فراری پوروسانگوئه G ادیشن کیوانی، دایناسور زرد ۱.۵ میلیون دلاری!
-
دیدار رئیس پارلمان عراق با کاردار آمریکا بر سر سرنوشت پایگاه عینالاسد
-
شوهرم در رسیدگی به بچهها ابدا کمک نمیکند
-
رونمایی از لوگو هیئت فوتبال استان تهران با حضور مهدی تاج
-
استانداری مازندران به پنل خورشیدی مجهز شد
-
رئیس کل گمرک: طلای وارداتی بابک زنجانی قاچاق نبوده است
-
تمدید کنسرت «ایرانم» علیرضا قربانی
-
بهروز سلطانی: وقتی از برخی ایجنت ها بازیکنی جذب پرسپولیس نمی شود
-
بهروز سلطانی: وحید هاشمیان مدیریتی در سطح علی پروین دارد، اگر به حاشیه نرود صد درصد موفق می شود
-
حضور مهدی تاج در مجمع سالیانه هیئت فوتبال تهران
پربیننده ترین
-
عکس مسی درآمد؛ آخرین توپ طلا با آرایشگر ویژه!
-
10 جایزه 5 میلیون تومانی برای کاربران آخرین خبر (مهلت شرکت در مسابقه تا 9 آذر تمدید شد.)
-
10 جایزه 5 میلیون تومانی برای کاربران آخرین خبر (مهلت شرکت در مسابقه تا 9 آذر تمدید شد.)
-
چراغ قوه همه کاره ( پاور بانک، شیشه شکن و ... )
-
هشدار آبفای کشور به مردم؛ هیچ ماموری فعلا برای قرائت کنتور آب مراجعه نمیکند
-
آخرین وضعیت راهها در چهارمین روز از سال جدید؛ محور چالوس از شنبه دوباره بسته میشود
-
جارو شارژی !! دیگه نگران نظافت ماشین نباشید
-
زنده؛ بیرانوند در یک قدمی استقلال
-
"دنا پلاس اتومات" بخریم یا "تارا اتومات؟"/ مقایسه اختصاصی "آخرینخودرو" از دو خودروی پرطرفدار
-
فشار آبرو چند برابر کن ....
-
فرمانده کل قوا: ملت ایران در مقابل جنگ تحمیلی محکم میایستد همانگونه که در مقابل صلح تحمیلی نیز محکم خواهد ایستاد
-
چالش/ بازیکن داخل تصویر رو حدس بزن (16)
-
5 نشانه ضعیف شدن ریه ها و بهترین روش تقویت آن چیست؟
-
لندکروزر یا ۲۰۶؟ / مقایسه جالب "آخرینخودرو" به بهانه سخنان جنجالی میرسلیم
-
پایان زودهنگام گنبد آهنین؟ اسرائیل مجبور به جیرهبندی موشکها شد
-
سپ، برترین شرکت در خاورمیانه شد
-
گردونه را بچرخانید، بیتکوین دریافت کنید
-
واکنش عراقچی به تجاوز امروز آمریکا به تأسیسات هستهای فردو، نطنز و اصفهان